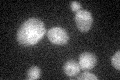
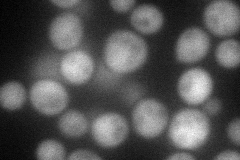
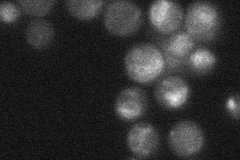
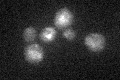

View description
Vacuolar protein with a possible role in sequestering heavy metals; has similarity to the type V P-type ATPase Spf1p; homolog of human ATP13A2 (PARK9), mutations in which are associated with Parkinson disease and Kufor?Rakeb syndrome
Localization:
Intensity:
Fold change:
Significance:
-
C’ GFP library in SD
ER25.41 -
N' NOP1pr-GFP in SD

vacuole membrane77.1964 -
N' TEF2pr-mCherry in SD
cytosol68.1045 -
N' NATIVEpr-GFP in SD
vacuole membrane22.2156 -
N' TEF2pr-VC and Cyto-VN in SD

below threshold24.699 -
C’ GFP library in SD+DTT

ER22.730.89No -
C’ GFP library in SD+H2O2

ER23.340.91No -
C’ GFP library in Starvation Media
ER25.340.99No -
C’ GFP library on the background of Pup2-DaMP

ER -
C’ GFP library on the background of CCT mutant

ER21.7590.856199No
